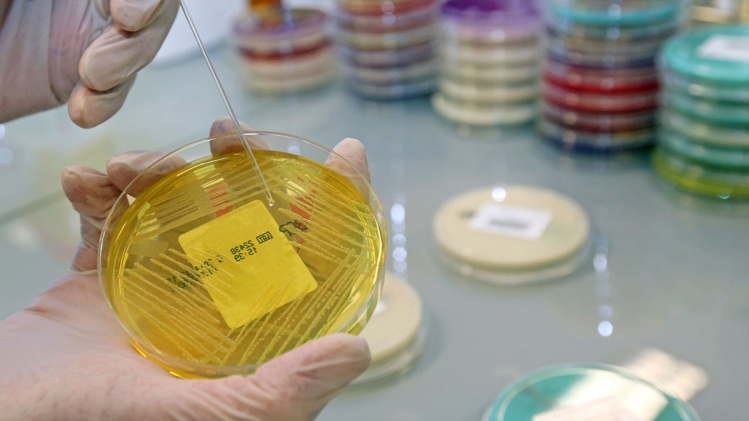
bactérie.jpg

Partager:
Depuis le début de l’année 2025, 26 personnes ont été hospitalisées en Louisiane après avoir contracté la bactérie Vibrio vulnificus. Cinq d’entre elles sont décédées. En 2024, un seul décès avait été recensé dans cet État.
L’inquiétude s’étend à tout le sud des États-Unis : entre 150 et 200 cas sont signalés chaque année dans les États côtiers du Golfe du Mexique comme le Texas, le Mississippi ou la Floride. Selon les Centres pour le contrôle et la prévention des maladies (CDC), les infections ont été multipliées par huit entre 1988 et 2018.
Une bactérie agressive, parfois fatale en 48 heures
Vibrio vulnificus provoque des infections cutanées très rapides, avec une propagation qui donne l’impression que la peau est « mangée ». Elle peut aussi entraîner des symptômes digestifs ou une septicémie. Le taux de mortalité varie de 20 à 50 %, et la mort peut survenir en moins de 48 heures après l’infection.
Cette bactérie vit dans les eaux chaudes et saumâtres, comme les estuaires ou certaines plages. Elle peut s’attraper en mangeant des huîtres crues ou en se baignant avec une plaie ouverte. D’après une étude publiée en mars 2025 dans la revue Nature, Vibrio vulnificus se développe dès que l’eau dépasse 15°C. Elle est donc particulièrement active entre mai et octobre. Le réchauffement climatique rend ces conditions de plus en plus fréquentes.
Comme le soulignent les chercheurs, « ces infections ne sont plus confinées au sud des États-Unis ». Depuis quelques années, la bactérie remonte vers le nord. En 2023, des cas ont été identifiés dans des États plus froids comme New York, le Connecticut ou la Caroline du Nord. En août 2025, un nageur a été contaminé au Massachusetts après être allé dans l’eau avec une plaie.
L’étude de Nature indique que les États-Unis ne sont pas les seuls concernés. Les côtes de la mer Baltique et certaines régions d’Asie de l’Est sont aussi touchées. En 2016, la Polynésie française avait enregistré la plus forte concentration relative de cette bactérie.
![Bus_dépôt[1].jpg](https://rtleng.rosselcdn.net/sites/default/files/dpistyles_v2/rtl_16_9_644w/2026/02/06/node_779046/4522288/public/2026/02/06/62040072.jpeg?itok=bNSNk4nM1770407490)






![Bus_dépôt[1].jpg](https://rtleng.rosselcdn.net/sites/default/files/dpistyles_v2/rtl_16_9_1440w/2026/02/06/node_779046/4522288/public/2026/02/06/62040072.jpeg?itok=kTlfYnbO1770407490)










